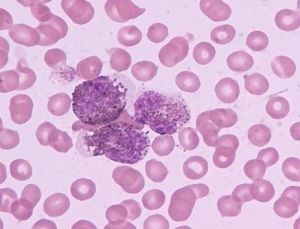
原發性皮膚T細胞淋巴瘤 原發性皮膚T細胞淋巴瘤

臨床表現
外部位淋巴組織的免疫1.紅斑期
皮損無特異性,可類似於慢性單純性苔蘚樣變、濕疹、慢性接觸性皮炎、脂溢性皮炎、特應性皮炎、副銀屑病等,多伴有劇烈頑固性瘙癢。
2.斑塊期
可由紅斑期發展而來或直接在正常皮膚上發生。皮損呈形態不規則、境界清楚、略高起的浸潤性斑塊,顏面暗紅至紫色,可自行消退、也可以融合形成大的斑塊,邊緣呈環狀,弓形或匍行性,顏面受累時皮膚皺褶加深形成獅面樣。
3.腫瘤期
皮損呈褐紅色隆起性結節,大小、形狀各異,易早期破潰,形成深在性卵圓形潰瘍,基底被覆壞死性灰白色物質,潰瘍邊緣捲曲;繼發感染可伴有疼痛及惡臭。患者常在數年內死亡。偶亦見開始既表現為腫瘤而未經紅斑期或斑塊期皮損者,稱暴力型皮膚T細胞淋巴瘤,預後差。
除皮膚外,淋巴結最常受累,其他依次為脾、肺、肝、骨髓、腎臟、舌會厭、心臟、胰腺和甲狀腺,內臟受累往往在屍檢時才能發現。
診斷
紅斑期皮損及組織病理均無特異性,往往難於作出診斷。臨床上對擬診其他慢性瘙癢性皮膚病但常規治療方法無效者,應考慮本病,必要時多次及多部位取材,並作連續切片觀察,以早期作出診斷。斑塊期及腫瘤期根據臨床表現,結合組織病理表現可作出診斷。
原發性皮膚T細胞淋巴瘤真皮浸潤中多數T細胞(80%~90%)為鋪助性T細胞,僅10%~20%為抑制性T細胞,因此套用抗T細胞單克隆抗體進行免疫過氧化酶染色有助於診斷;此外T細胞受體的基因重排亦為診斷提供了較為特異的手段。
治療
早期皮損以增強患者免疫力和局部治療為主,可用干擾素、卡介菌或轉移因子等。局部治療可選用氮芥或芳香維A酸外用,電子束照射,X線、光化學療法等均有一定療效。晚期患者應採用化療(如環磷醯胺等),與局部治療聯用可獲更好療效。